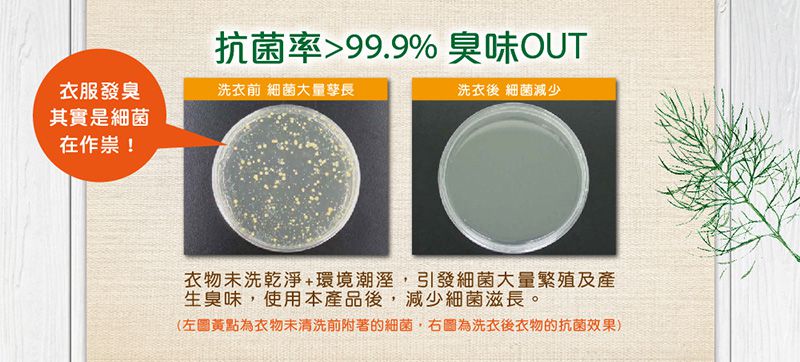
毛寶 maobao - 小蘇打植萃香氛液體皂-制臭抗菌-1800g

首載 App 現領 $ 100 折價券
 ( 10000+ )
( 10000+ )
1/1
商品特色
英國有機認證天然精油,讓衣服森呼吸
棕櫚/椰子油皂+小蘇打配方,可深入衣物纖維去除污垢
日本專利植萃淨味,有效終結異味
葡萄柚籽抗菌,抑菌率達99.9%
低泡沫好沖洗,洗淨不殘留

口碑嚴選

正品保證

加密付款

7天鑑賞
付款
信用卡・LINE Pay・街口支付・先享後付・ATM・貨到付款
配送
宅配
滿$999免運
超商取貨
滿$999免運
註冊新會員立即領首購免運券
介紹
- 英國有機認證精油 讓衣服森呼吸
嚴選英國Soil Association天然有機認證玫瑰天竺葵精油,讓您從洗衣到穿衣感受大自然的療癒與呵護,天然純淨零負擔。
- 棕櫚/椰子油皂+小蘇打 加乘清潔力
純淨天然棕櫚/椰子油精煉液體皂,與食用級小蘇打黃金比例調合,軟化水質,深入衣物纖維去除污垢。
- 日本專利植萃淨味 終結異味
採用200多種植物萃取而成的淨味精華,有效包覆、分解、中和異味分子,終結各種惱人異味。
- 葡萄柚籽抗菌 天然防禦力
抑制大腸桿菌、金黃色葡萄球菌、綠膿桿菌、沙門氏菌、黑黴菌等常見壞菌滋生,抑菌率>99.9%
- 低泡沫好沖洗 洗淨不殘留
低泡沫配方,好沖洗,不易殘留於衣物纖維,洗淨力不打折。適用於滾筒式與直立式洗衣機。

看更多

